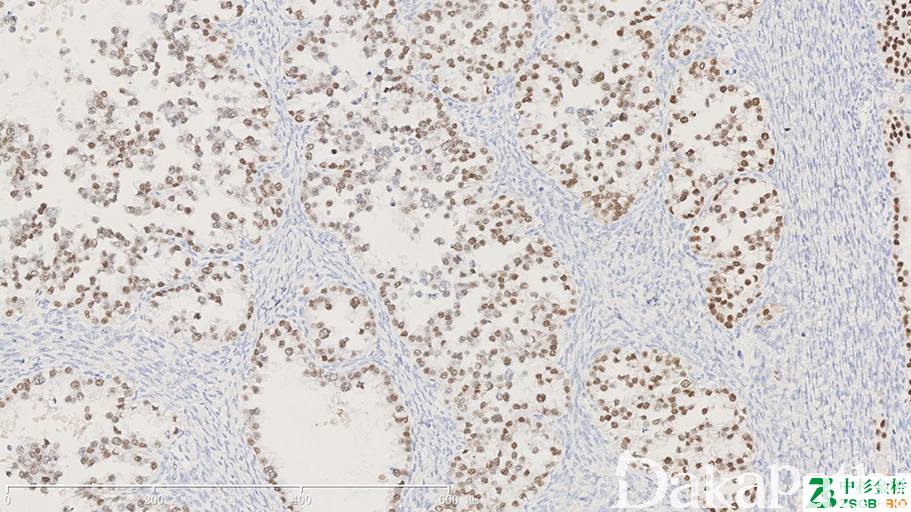

HNF-1-β

别名: hepatocyte nuclear factor 1-alpha;HNF1beta;LFB3; MODY5;TCF2; VHNF1;
概述:
homeodomain-containing 转录因子家族中的一员,肾单位功能发育和调节胚胎胰腺发育中起重要作用。这个基因的突变导致肾囊肿和糖尿病综合症和 noninsulin-dependent 糖尿病,和表达的基因改变某些类型的癌症表达在胃肠道腺上皮细胞,尤其是阑尾、胆囊中高表达,同时在肾小管中亦高表达。
信号定位: 胞核
在病理学中的应用:
透明细胞癌的鉴别诊断
商品化试剂(排名不分先后,本网站对抗体质量不负责!)
公司 | 克隆号 | 即用型(ml) | 原液(ml) | ||||
中杉金桥 | / | 1.5 | 3 | 6 | / | 0.1 | 0.2 |
